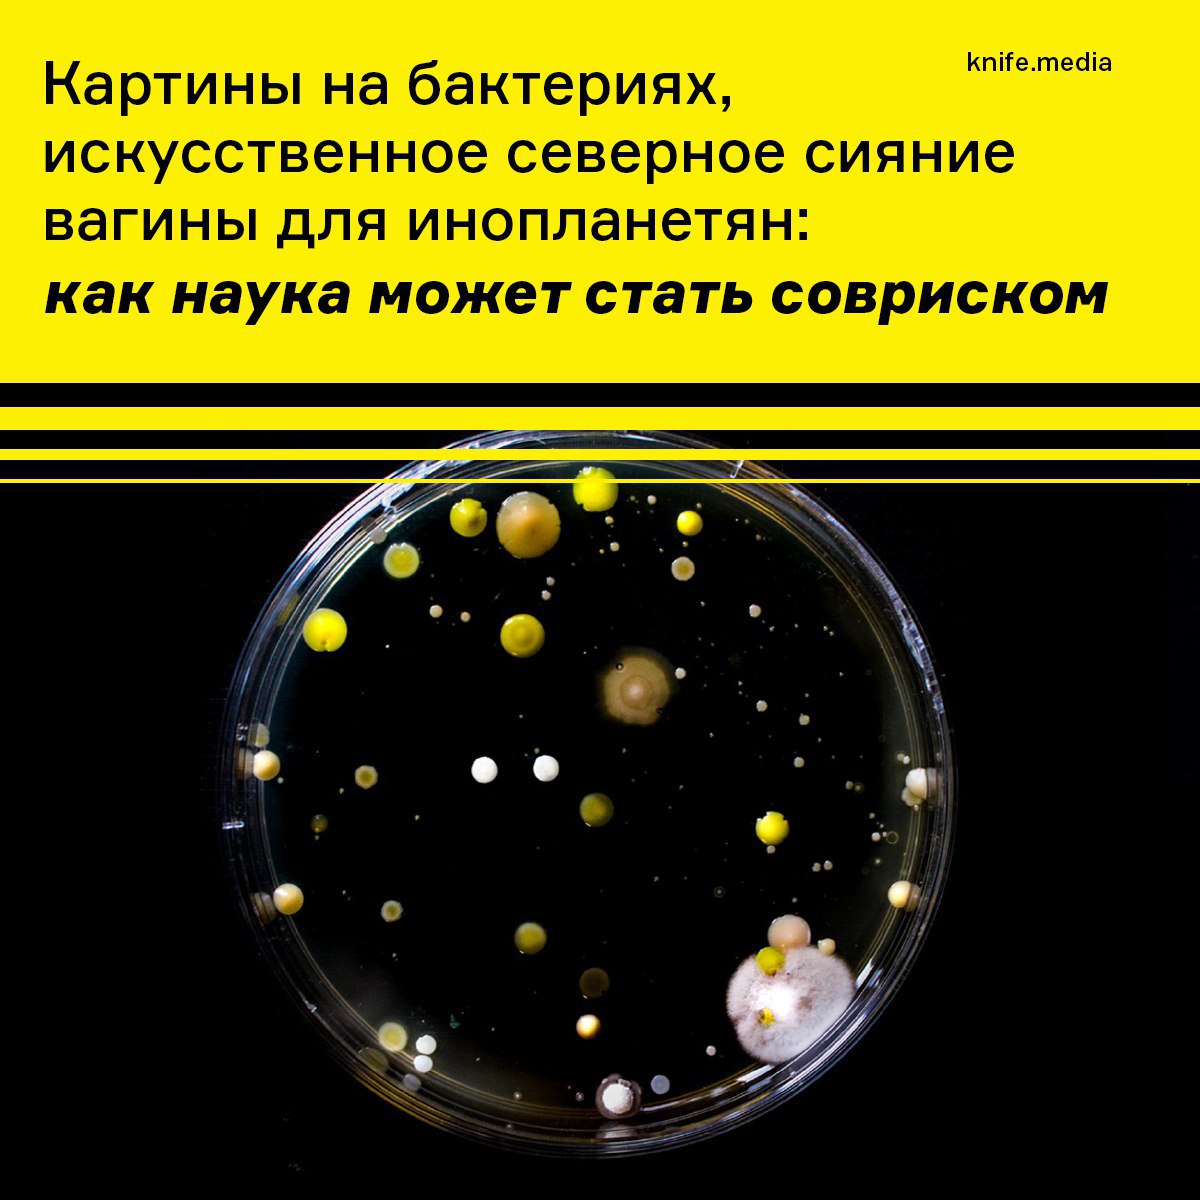

В
журнале «Нож» вышел мой новый текст.
Монологи ВИЧ-позитивных геев. Доконтактная терапия, бесплатные тесты. Мои собственные переживания.
"Полгода назад (весной) я встретился с парнем. Депрессия и неудачная романтическая история заставляли меня искать одноразовые приключения. В тот вечер все началось с алкоголя. Потом — прелюдия и его странная фраза «Меня нельзя ебать». Это последнее, что я помню", — я.
Героям спасибо за открытость (хотелось всех обнять) 🏳️🌈💙
https://knife.media/hiv-russia/